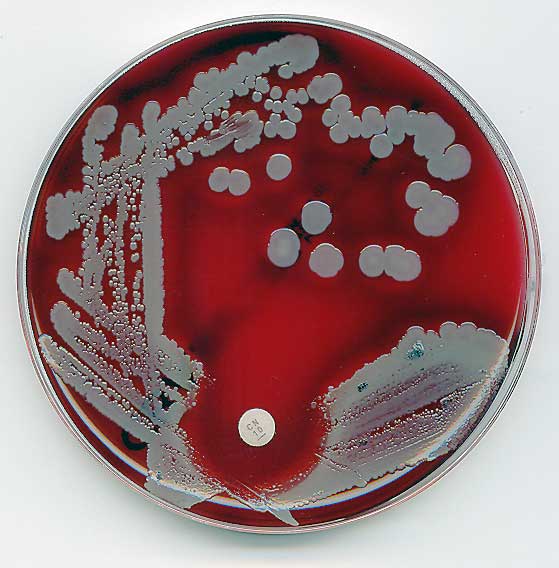
Setting Priorities: What Research is Worth Funding?

Author: Britta Glennon
-

The Role of Technology in Crisis Management and How it Could be Done Better
•
This piece, first published on May 7, 2013, is being republished as part of the Chicago Policy Review‘s 20th Anniversary Series. Please visit us here to learn more about the series from our Executive Editors. While a fast and comprehensive means of reporting breaking news, social media brings with it the risk of misreporting, which in…
-

Hoping to Create Your Own Silicon Valley? Don’t Count On Returnee Entrepreneurs
•
Developing countries might be better off spending their resources on establishing the right policy environment for local entrepreneurs.
-
Setting Priorities: What Research is Worth Funding?
•
Kei Koizumi from the White House Office of Science and Technology Policy discusses how his office thinks about R&D funding in a time of budget cuts and economic uncertainty.
-

Barriers for Highly Skilled Immigrants: Why should American firms care?
•
How would hiring more highly skilled immigrants impact American firms?
-

How Big is the Broadband Bonus?
•
A new study investigates the economic impact of broadband investment
-

It’s in Beta and Always Will Be
•
A broadband expert discusses the National Broadband Plan two years out
-

Cell Mates: Mobile Phones and Digital Access in China
•
Have mobile phones been effective in narrowing China’s digital divide?



